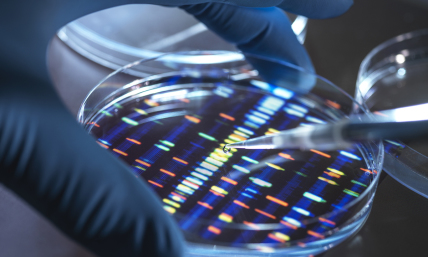
Is engineering a ‘super’ human being a good idea?

Is engineering a ‘super’ human being a good idea?
When we start trying to engineer human beings, we are in way over our heads ethically and morally.


Dr. Richard Land, BA (magna cum laude), Princeton; D.Phil. Oxford; and Th.M., New Orleans Baptist Theological Seminary, was president of the Southern Baptists’ Ethics & Religious Liberty Commission (1988-2013) and has served since 2013 as president of Southern Evangelical Seminary in Charlotte, NC. Dr. Land has been teaching, writing, and speaking on moral and ethical issues for the last half century in addition to pastoring several churches.
When we start trying to engineer human beings, we are in way over our heads ethically and morally.
Millions of Americans awakened Thursday morning to the news that Dr. James Dobson has departed to his heavenly reward at the age of 89. Dr. Dobson played a huge role in what he called the “Civil War of Values” in America from the 1970s until the present day.

As followers of Jesus Christ our risen Lord and Savior, we are preparing to celebrate our most sacred and important event — the Resurrection of our Savior, Jesus the Messiah.

One of the most common sayings in the English language is "the straw that broke the camel's back," signifying the gradual accumulation of heavy burden until finally, one additional blade of straw collapses the camel to his knees, no longer able to successfully bear the burden.

As I sit in my study writing this column, I find myself in a contemplative mode. I have just experienced a Christmas season unlike any other in my eight decades of existence.

I want to challenge Christian groups on college campuses and campus ministers to organize a concerted effort to accompany their fellow Jewish students to class and by their presence help protect Jewish students from harassment and abuse. Multitudes of Christians across America should make it clear that to get to our Jewish citizens you will have to come through us first.

The hideous Hamas terrorist attacks against Israeli civilians (including women, children, and infants) remind us that nothing in the Middle East happens in a vacuum and the ghosts of the past are always in the room with us.

The UDHR articulates in its 30 articles every human being’s basic, fundamental rights and freedoms and affirms those rights as universal and unalienable. The UDHR directly led to the development of the concept of international human rights law.

For me, someone raised in the segregated South, having attended segregated schools, a segregated church, and living in a segregated neighborhood, his sermon to America was a clarion call to commitment and action in support of a cause that was demanded both by our founding documents and, more importantly, by the Gospel proclaimed in the New Testament.

In one of the last public addresses Dr. Adrian Rogers delivered before his untimely demise at the age of 74, he warned pastors of the mortal threat presented to their ministries by the sins of lust and pride.

Jack Smith’s prosecution (or was it “persecution”) of Gov. Bob McConnell was so overly zealous that it provided an extremely rare unanimous Supreme Court repudiation of it. Bob McConnell’s legal expenses amounted to a devastating $27 million.

I must confess that I have never penned a column with a heavier heart. My beloved country, the United States of America, is in trouble.

"God in Eternity and Time" has been well received by all segments of the Evangelical community, and its irenic spirit has been much appreciated, drawing accolades from across the Evangelical theological spectrum.

It's not often I am surprised by comments that are generated by my columns in The Christian Post. So imagine my surprise at being taken aback by some comments generated by my July 4th column.

Many people thought that after the U.S. Supreme Court’s binge of rulings at the end of June, the July Fourth holiday would be free of judicial turmoil. Boy, were they wrong!

For those tens of millions of Americans who lived through the American experience of the war in Vietnam, it was almost without exception an excruciating and life-shaping experience.

On Tuesday, the United States Supreme Court heard oral arguments on a civil rights and religious liberty case Groff v. DeJoy that may well have a significant impact on the religious freedom of American workers.

Most Americans alive today are not aware that in the last half of the 19th century, President Ulysses S. Grant was probably the most admired man in America with the exception of President Abraham Lincoln.

The culture wars of the last half of the 20th century and the first third of the 21st century in America have produced some previously unimaginable alliances.

Occasionally a book tells such an extraordinary story that it makes for compelling and inspirational reading. Leadership Not by the Book by David Green with Bill High is just such a book.
